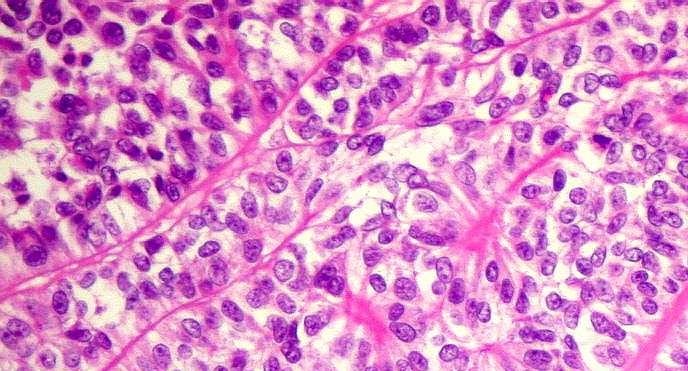
DSCN38799+ DSCN38799 1
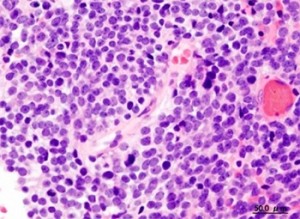
Experimentos in vitro de foram feitos com linhagens de meduloblastoma, o tipo de cáncer cerebral más común en niños (imagen: Wikimedia Commons)

Vía Agencia Fapesp
Investigadores del Instituto de Biociencias de la Universidad de São Paulo (IB-USP) estudian un grupo de genes humanos que, cuando se expresan en tumores malignos, confieren a las células tumorales propiedades similares a las de las células madre, haciéndolas más agresivas y resistentes a tratamiento.
experiencias in vitro foram feitos com linhagens de meduloblastoma, o tipo de cáncer cerebral más común en niños. Foro de resultados recientes publicados en revistas Células madre y desarrollo. y ciencia del cáncer.
“Estos genes, cuando se expresan, no son simples marcadores de mal pronóstico. Contribuyen positivamente a la agresividad tumoral. Entonces, entonces, nuevas terapias por explorar”, dijo Oswaldo Keith Okamoto, docente del IB-USP e integrante del Centro de Estudios del Genoma Humano y Células Madre (CEHG-CEL), dos Centros de Investigación, Innovación y Difusión (CEPID) apoyados por la FAPESP.
El grupo coordinado por Okamoto tem se dedica a estudiar el papel de cuatro genes que codifican factores ligados a la pluripotencia: OCT4, L1TD1, LIN28 y miR-367. Este último, en lugar de una proteína, codifica un microARN (un pequeño fragmento de ARN que no contiene información para la producción de proteínas pero que tiene un papel regulador en el genoma).
Según el investigador, estos cuatro genes deberían expresarse mayoritariamente en las células madre embrionarias existentes durante la primera semana después de la fecundación.
“En esta fase, o embrión, está formado por una estructura conocida como blastocisto y dentro de este hay una masa de células madre embrionarias que expresan factores relacionados con la pluripotencialidad que son importantes para esta etapa del desarrollo”, explicó.
Sin embargo, los análisis de las bases de datos de expresión revelarán que estos mismos genes se expresan con frecuencia en muestras de meduloblastoma, lo que otorga a las células tumorales ciertas propiedades de células madre, como una alta capacidad de autorrenovación (generación de nuevas células madre) y diseminación corporal.
Estudios previos del grupo de Okamoto habían demostrado que la presencia de este tipo de células madre tumorales se correlacionaba con una menor supervivencia de los pacientes y un mayor riesgo de metástasis.
“Se han realizado varios estudios en los últimos 15 años para comprender el papel de las células madre tumorales, que se han observado en varios tipos de cáncer, incluidos los de mama y próstata. Tienen relevancia clínica, ya que son más tumorigénicos, tienen mayor capacidad de autorrenovación, mayor capacidad de esparcir pelos y colonizar sitios distantes, y son más resistentes al tratamiento.Okamoto.
Según el investigador, todavía no sabemos con certeza cómo se forman las células madre tumorales. Es posible que sean el resultado de una transformación maligna de una célula madre normal. Otra hipótesis es que una célula maligna adquiere nuevas alteraciones genéticas que le confieren las características típicas de las células madre.
“Para ciertos tumores de origen embrionario, como es el caso del meduloblastoma, existe evidencia de que durante el proceso de maduración de dos órganos, ciertos genes activos en las células madre embrionarias deben desconectarse durante el desarrollo del embrión, por alguna razón. , razón, no são. Evitaría que estas células se diferenciaran adecuadamente. Si se vuelven genéticamente inestables, pueden dar lugar a un tumor. Esa es una hipótesis plausible», dijo Okamoto.
experiencias
Durante o después del doctorado de Márcia Cristina Teixeira dos Santos, realizado en la Beca FAPESP, se investigó con mayor profundidad el papel del gen L1TD1.
Utilizando una técnica conocida como interferencia de ARN, que implica el uso de pequeñas moléculas de ARN que no codifican proteínas capaces de unirse al ARN mensajero del gen e interrumpir su expresión, o un grupo silenciador en dos meduloblastomas L1TD1 o linhagens para ver si el procedimiento afectado una propiedad importante para la agresividad del tumor.
Unas 48 horas después del silencio, sin ningún otro tipo de intervención, solo el 50% de las células tumorales seguían vivas. Después de 96 horas, aproximadamente el 80% de las células ya estaban muertas.
La capacidad de migración e invasión celular, fundamental para la generación de metástasis, disminuye por menos de este período. También se observó una reducción en la proliferación de taxones y resistencia a la muerte por apoptosis (una especie de suicidio celular).
En otro ensayo, los investigadores observaron que silenciar L1TD1 hace que las células tumorales respondan mejor al tratamiento de quimioterapia. Usando una dosis que normalmente sería suficiente para matar el 40 % de las células en cultivo, pudimos matar alrededor del 70 % después del procedimiento.
En la evaluación de Okamoto, por lo tanto, el resultado más interesante se obtuvo en la prueba de generación de neuroesferas.
“Cuando aislamos las células madre neurales normales y las cultivamos en el laboratorio, se convierten en estructuras llamadas neuroesferas. Normalmente, sucede lo mismo cuando cultivamos células madre tumorales de meduloblastoma. Pero cuando silenciamos L1TD1, la capacidad de generar neuroesferas disminuyó alrededor de un 75%”, dijo el investigador.
Estudios previos han demostrado que cuanto mayor es la capacidad de las células tumorales para generar neuroesferas, más agresivo es el tumor y menor la supervivencia del paciente.
“También observamos que el silenciamiento génico disminuye la expresión de proteínas que son marcadores típicos de las células madre neuronales, como CD133 y nestina. Por tanto, existe una correlación directa entre la expresión de este gen y la adquisición de las propiedades típicas de las células madre. Por inferencia, creemos que este gen es importante para la proliferación tumoral y la resistencia a los fármacos quimioterapéuticos”, dijo Okamoto.
En otro trabajo, realizado durante la docencia de Carolini Kaid Dávila, también con Apoyo da FAPESP, o foco de fe o microARN miR-367. Pero esta vez, en lugar de silenciar el gen, los investigadores inducen una súper expresión.
“Nas linhagens de medulloblastoma com as quays trabalhamos, or miR-367 é small espresso. Silencio, eso probablemente no tendría mucho impacto. Una superexpressão, por otro lado, ayuda a resaltar su efecto y hacerlo visible”, explicó Okamoto.
Para ello, nuestro grupo inyecta directamente en las células tumorales moléculas sintéticas de microARN que imitan la secuencia de nucleótidos que se encuentra en el miR-367.
«Este microARN sintético tiene la misma secuencia que el original, más algunas pequeñas alteraciones químicas que hacen que la molécula sea más estable dentro de la célula, por lo que permanece el tiempo suficiente para ser observado o afectado», explicó.
El método se aplicó a cuatro linfógenos de meduloblastoma y en cada uno de ellos se observó, en mayor o menor grado, un aumento de la proliferación y de la invasividad tisular.
Para Okamoto, sin embargo, el resultado más significativo fue nuevamente la capacidad de generar neuroesferas. “Variedad de linhagem por linhagem, pero en algunos casos hay que pagar. Estas neuroesferas expresan marcadores típicos de células madre neurales, como proteínas CD133 y nestina”, disse.
El investigador destaca que en ambos grupos de trabajos se modificó para expresar más de un gen simultáneamente.
“La modificación de la expresión de un solo gen ligado a la pluripotencialidad fue suficiente para alterar significativamente el potencial agresivo del tumor. Por lo tanto, creemos que interferir con L1TD1 o cualquier otro deseo sería una buena estrategia para reducir la resistencia a los medicamentos e inhibir la recurrencia del tumor”, concluyó.
o artículo La proteína L1TD1 relacionada con las células madre embrionarias es necesaria para la viabilidad celular, la formación de neuroesferas y la quimiorresistencia en el meduloblastoma (DOI: 10.1089/scd.2015.0052) puede ser asesinado por da killers Células madre y desarrollo. aquí.
o artículo miR-367 promueve la proliferación y los rasgos similares a bastones en células de meduloblastoma (DOI: 10.1111/cas.12733), puede ser asesinado por da killers ciencia del cáncer aquí.